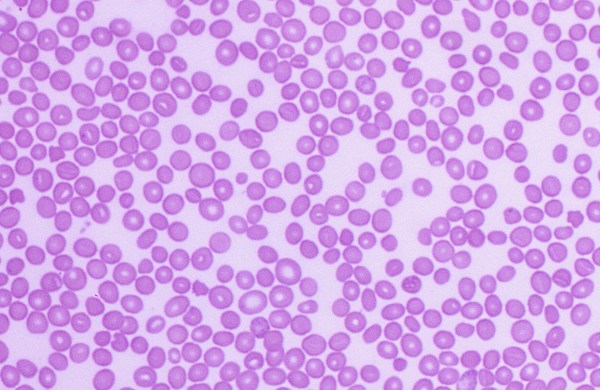

Monocytes
Morphology: leukocytes with pleomorphic nuclei (usually lobulated but may be round or kidney-shaped) and blue-gray cytoplasm containing occasional vacuoles or fine pink granules. Monocytes are larger than most other leukocytes.… Read more Monocytes →